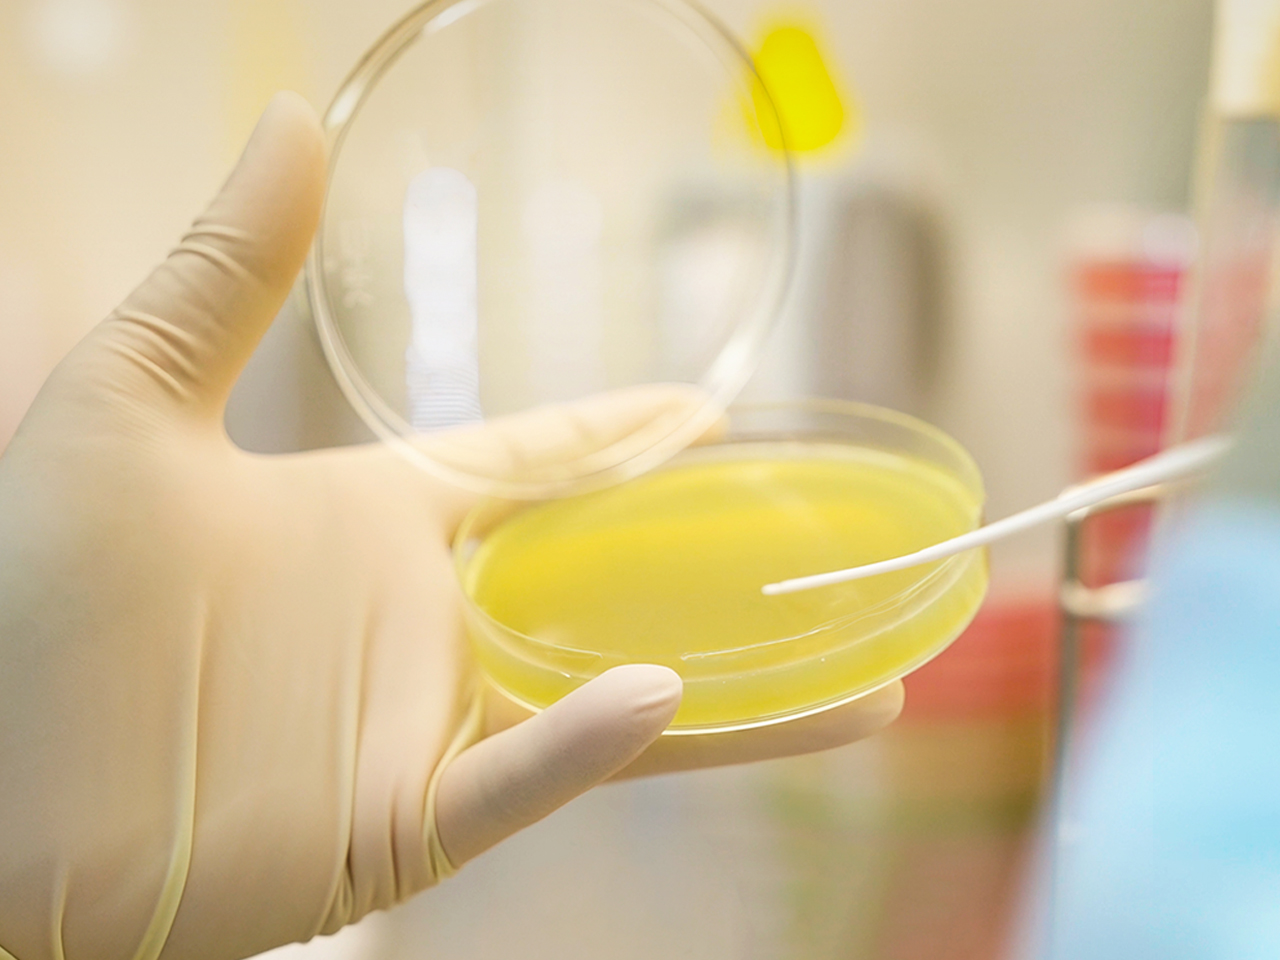
3.jpg

近日,有机婴童零辅食领域领军品牌“爷爷的农场”再迎里程碑式突破,品牌实力获得权威肯定。

爷爷的农场在持续整合优质供应链资源的基础上,同步推进自主智造能力布局,形成“自有+协同”双轨并行的产能体系。目前,其位于广州增城的生产基地被正式认定为广州市第一家获得婴幼儿辅助食品(特殊膳食)生产资质的工厂,获准生产国家标准GB 10770(婴幼儿罐装辅助食品)与GB 22570(辅食营养补充品)相关产品。这也标志着该基地成为广州市首家同时取得这两类特殊膳食食品生产许可的单位。
作为广州市首家获得该生产资质的单位,爷爷的农场建立了严苛的品控体系,确保产品符合高品质标准。据人民网报道,爷爷的农场增城基地占地24000平方米,配备多个10万级净化车间、多条智能化高精度生产线与婴幼儿特殊膳食产品高标准检测实验室,生产管理严格遵循ISO9001、BRCGS、IFS质量管理体系。环境层面,工厂采用洁净封闭式车间,通过智能化的灌装、压盖、喷码、贴标流水线完成生产,为宝宝食品安全保驾护航。

此外,爷爷的农场建立了领先于行业的“出厂自检+权威机构批检”双重品控体系:第一道防线是工厂采用国际先进的检测设备,对每批产品的营养成分、理化指标、安全指标等进行严格出厂自检;通过后再送往国家认可的权威第三方检测机构进行“复核”,合格后方可投放市场。
据了解,2020年至今,爷爷的农场已累计完成超过一万批次的产品送检,专项检测费用投入累计超过1500万元。增城工厂于2024年10月投入使用,并已完成辅食用油、果汁产品、婴幼儿辅助食品(如猪肝粉)等特殊膳食产品小规模投产,后续将逐步扩大自主生产的品类范围。
爷爷的农场相关负责人表示:“被认定为广州首家,是对我们自主生产能力与品质管控体系的权威肯定,也是对我们多年来坚守品质的认可与激励。这标志着爷爷的农场正式迈入‘自主智造+品质定义’的新阶段。未来,我们将继续以更高标准守护宝宝的‘口粮安全’,让每一个家庭都能放心选择。”
消费日报网版权及免责声明:
1. 凡本网注明“来源:消费日报网” 的所有作品,版权均属于消费日报网。如转载,须注明“来源:消费日报网”。违反上述声明者,本网将追究其相关法律责任。
2. 凡本网注明 “来源:XXX(非消费日报网)” 的作品,均转载自其它媒体,转载目的在于传递更多信息,并不代表本网赞同其观点和对其真实性负责。
3. 任何单位或个人认为消费日报网的内容可能涉嫌侵犯其合法权益,应及时向消费日报网书面反馈,并提供相关证明材料和理由,本网站在收到上述文件并审核后,会采取相应措施。
4. 消费日报网对于任何包含、经由链接、下载或其它途径所获得的有关本网站的任何内容、信息或广告,不声明或保证其正确性或可靠性。用户自行承担使用本网站的风险。
5. 基于技术和不可预见的原因而导致的服务中断,或者因用户的非法操作而造成的损失,消费日报网不负责任。
6. 如因版权和其它问题需要同本网联系的,请在文章刊发后30日内进行。
7. 联系邮箱:xfrbw218@163.com 电话:010-67637706